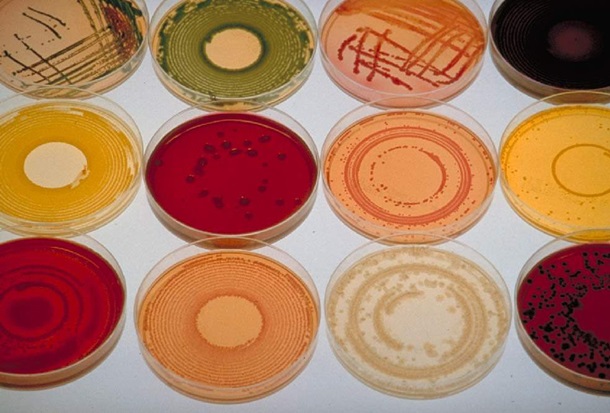

Злоупотребление антибиотиками привело к появлению устойчивых и смертельных бактерий. Если не принять меры, то медицину может отбросить на сто лет назад.
Проблему растущей устойчивости бактерий к антибиотикам подняли на Всемирном экономическом форуме в Давосе в этом году.
Британский министр здравоохранения Мэтт Хэнкок призвал «предотвратить ужасное будущее», в котором люди будут безоружны перед супербактериями и супермикробами. Он сравнил масштаб проблемы антибиотикорезистентности с войнами и изменением климата.
Еще в 2014 году ВОЗ объявила устойчивость к лекарствам, особенно к антибиотикам, возрастающей угрозой. Наступление эпохи без антибиотиков превратилось из апокалиптической фантазии в весьма реальную вероятность 21 века, говорят в организации.
Устойчивость к антибиотикам приводит к примерно 700 тысячам смертей в год. Она также подрывает способность медицины лечить рак, пересаживать органы и вставлять протезы, эти цифры будут только расти.
Если не принять меры, то к 2050 году супербактерии будут убивать около десяти миллионов человек, показывают исследования. Корреспондент.net рассказывает подробности.
Антибиотики: от спасения к губительным супербактериям
Еще менее века назад практически любая инфекция могла убить молодого и здорового человека. Малейший порез или простейшее хирургическое вмешательство были сродни лотерее: попадание бактерий в рану могло привести к смерти.
Однако с момента открытия пенициллина в 1928 году человеческий потенциал для борьбы с патогенными организмами рос. Начиная с 40-х годов, количество смертельных исходов резко пошло на убыль. Во всем мире были спасены миллионы человеческих жизней.
Но со временем количество антибиотиков, к которым чувствительны бактерии, уменьшалось, а некоторые стали устойчивыми к большинству или всем существующим лекарствам. В результате инфекции, которые поддавались лечению, вновь стали смертельными.
Опасен для здоровых. Новое исследование аспирина
Растущей устойчивости к антибиотикам способствовало множество факторов. Бактерии могут быстро размножаться и мутировать, передавая гены, устойчивые к антибиотикам. Большая часть антибиотиков — это продукты почвенных бактерий, поэтому устойчивость к антибиотикам может появиться естественным путем.
На данный момент в мире выпускается около 100-200 тысяч тонн антибиотиков в год, 70 процентов из которых применяют в сельском хозяйстве и только 30 процентов используются для лечения людей, при этом, они часто назначаются неправильно или без необходимости.
Дикие животные также сталкиваются с антибиотиками, поскольку значительная часть используемых препаратов сбрасывается в окружающую среду сточными водами и навозом.
Чем больше антибиотиков потребляется или сбрасывается в природу, тем быстрее вырабатывается устойчивость, приводящая к возникновению супербактерий, которые угрожают человеку.
Они повышают риск массовых, смертельно опасных эпидемий. Если не будет действенных антибиотиков, рядовые медицинские процедуры типа операции на бедре, кесарева сечения и химиотерапии станут намного опаснее, а некоторые медицинские вмешательства типа пересадки органов или химиотерапии будут неизменно иметь летальный исход. Медицину отбросит на сто лет назад.
Ситуация усугубляется еще и тем, что люди слишком часто пользуемся антибиотиками, принимая их в неправильной дозировке. Если не завершить курс лечения, или давать антибиотики животным в малых дозах для повышения их веса, создаются условия, в которых самые слабые супербактерии погибают, а самые сильные выживают и размножаются.
Чрезмерное использование антибиотиков также убивает полезные бактерии в человеческом организме, может нарушить кишечную флору и ослабить иммунную систему. Это приведет к более частым и длительным болезням и смертям от резистентных инфекций, против которых у современной медицины нет лекарств.
Getty
По заданию правительства Великобритании было проведено исследование, которое показало, что к 2050 году устойчивые к антимикробным препаратам инфекции будут убивать десять миллионов человек по всему миру. Это больше смертей, чем от онкологических заболеваний.
Одна из самых пугающих особенностей сегодняшнего кризиса антибиотикоустойчивости заключается в том, что фармацевтические компании не создают новые лекарства для борьбы с ней из-за низкой прибыли.
При этом с 1980-х годов принципиально новых антибиотиков практически не появлялось. За последнее десятилетие на рынок поступило лишь незначительное количество новых антибиотиков.
Ящик Пандоры открыт. Первые дети с измененной ДНК
Александр Флеминг был удостоен в 1945 году Нобелевской премии за открытие пенициллина. Во своей речи при получении премии он сделал пророческое заявление.
«Настанет тот день, когда любой человек сможет купить пенициллин в любой аптеке. Но тогда возникнет опасность, что несведущий человек примет недостаточную дозу, которая не уничтожит микробов и повысит их сопротивляемость антибиотикам», — сказал Флеминг.
ВОЗ призывает сократить использование антибиотиков
Чтобы решить проблему устойчивости к антибиотиками, человечеству нужен глобальный план. Супербактерии перемещаются по миру так же легко, как и люди на самолетах.
«Необходим обязательный для исполнения международный правовой механизм, охватывающий вопросы доступа, сохранения и инноваций. Когда международное право получает мощный механизм реализации, оно становится самым сильным побудительным средством к действию для всех стран», — говорят в ВОЗ.
Для решения проблемы необхдимо рациональное использование антибиотиков и создание новых виды. Они не борются с вирусами и, например, при ОРВИ от них больше вреда, чем пользы.
Кроме того, по современным рекомендациям иногда даже бактериальные заболевания необязательно сразу лечить антибиотиками — нередко организм справляется с инфекцией сам, и к лекарствам можно прибегать, только если состояние ухудшилось.
Обманули рак. За что дали Нобелевскую по медицине
Но, что действительно важно, так это запрет на использование антибиотиков в сельском хозяйстве по всему миру.
Только эти две меры — которые могли бы быть приняты государственными регулирующими органами — позволили бы сократить использование антибиотиков на 80 процентов, существенно снизив рост резистентности к антибиотикам.
При этом важно заниматься профилактикой бактериальных инфекций и у животных, и у людей, но без использования антибиотиков. Например, распространять известные прививки и создавать новые; соблюдать элементарные правила гигиены в быту и следить за исполнением всех гигиенических предосторожностей в больницах.
Ученые в поисках решения
Не так давно исследователи поняли, что искусственно можно вырастить только один процент из всех существующих бактерий. Соответственно, неизвестно, с помощью каких веществ остальные 99 процентов бактерий борются друг с другом.
У ученых есть несколько идей, как справиться с проблемой устойчивости бактерий к антибиотикам. Одна из них — научиться выращивать эти 99 процентов бактерий.
Решение этой задачи предложил американский ученый Слава Эпштейн со своей командой. Они нашли несколько удачных химических соединений, и как минимум к одному из них даже в лабораторных условиях ни одна исследуемая бактерия не смогла выработать устойчивость.
Другой вариант — искать соединения в растениях. Кроме того, ведутся исследования: например, различных антител, бактериофагов и пробиотиков, то есть «хороших» бактерий.
Как оружие против супербактерий применили и квантовые наночастицы. Исследования показали, что наночастицы из серебра или золота могут быть эффективными в борьбе против антибиотик-резистентных инфекций, однако они также оказались токсичными для окружающих клеток организма.
Позже исследователи проверили действие квантовых точек из теллурида кадмия на бактерию Escherichia coli — одной из самых известных супербактерий. Было убито до 92 процента бактериальных клеток.
Далее исследователи продолжили испытание наночастиц на нескольких болезнетворных антибиотик-резистентных штаммах бактерий, рост которых уменьшился на 29-59 процентов.
И, наконец, ученые проверили действие квантовых точек на совместную культуру из E.coli и животных клеток HEK 293T, проверяя предположение, что наночастицы могут действовать избирательно. В результате рост E.coli был подавлен, а животные клетки остались неповрежденными.
Самая знаменитая супербактерия метициллин — резистентный золотистый стафилококк; но наряду с ним известны лекарственно-устойчивые штаммы туберкулеза, гонореи, кишечной палочки.
Новости от Корреспондент.net в Telegram. Подписывайтесь на наш канал https://t.me/korrespondentnet
источник: korrespondent.net
 Бизнес
Бизнес Общество
Общество Спорт
Спорт Происшествия
Происшествия Все города
Все города







 Перевести сайт на Украинский
Перевести сайт на Украинский Сео продвижение Одесса
Сео продвижение Одесса

